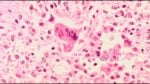

Welcome to Quantum Torah® Blog
Where Qabala* meets Quanta: Torah, science, and philosophy in dialogue. Short posts and deep essays that surprise, challenge, and inspire.

Why Ten? The Tetractys of the Divine Name
The number ten occupies a singular place in the architecture of the Torah. The world was created by the Ten Utterances (Asarah Ma’amarot). Egypt was
Is it Rational to Believe in God?
As a physicist, I found God in science. I cannot prove God’s existence because God does not exist in the ordinary sense; He transcends our
Is It Rational to Believe in God?
I was invited to contribute to “My Elevator Pitch for God”—a project that asks philosophers, theologians, and scientists to make their best case for God’s

Pesach as the Fulfillment of Creation
“Why is this night different from all other nights?” The child’s question at the Seder is asked about a single evening, but it opens onto

The Golden Calf as Hysteresis
לע”נ אמי מורתי רחל ב”ר דוד ע”ה The sin of the Golden Calf is among the most bewildering episodes in the Torah. A people who

Erasing the Memory of Amalek: Hysteresis, System-Memory, and the Thermodynamics of Redemption
Synopsis The essay resolves the apparent paradox in the Torah’s dual command to “remember what Amalek did” and simultaneously “erase the memory of Amalek” by

Exodus as a First-Order Phase Transition
Dedicated to the speedy and complete recovery of Rachel bat Sarah Introduction The Exodus from Egypt (Yetziat Mitzrayim) can be read as a rapid collective

Phase Transition: How Close Are We to the Geulah?
The Macro Instability Index and early warning signs of an approaching transition Synopsis This essay is the fourth installment in the series on dreams and

Phase Transitions in Human History
Metastability, nucleation, and the logic of tipping points Synopsis This essay develops a disciplined metaphor: the vocabulary of phase transitions in physics as a way

Phase Transitions II: Galut as Dream, Geulah as Awakening
When the Lord restored the fortunes of Zion, we were like dreamers.” (Psalms 126:1) Abstract This essay reads Exile (Galut) as a dream-state: a mode

Phase Transitions I: Sleep Architecture of Joseph’s Dreams
Synopsis The Joseph narrative in Genesis is stitched together with dreams—his own, the courtiers’, Pharaoh’s—yet the story itself unfolds according to the grammar of sleep.

G‑d Who Dreams: Creation, Companionship, and the Entropic Imagination
Synopsis This essay begins from the dream-saturated narratives of Vayetze, Vayeshev, and Miketz—Jacob’s ladder, Joseph’s dreams, and the dreams of Pharaoh and his ministers—and asks

Isaac and Rebecca: Deception or Wigner’s Friend Paradox?
Synopsis The narrative of the “stolen blessings” in Parashat Toldot presents a profound moral paradox: How could Rebecca, a righteous prophetess, and Jacob, the archetype
Isaac’s Blessing
Stars, Sand… and Silence Abraham’s blessings sparkle with cosmic imagery—stars above, dust below. But when God blesses Isaac, the patriarch of gevurah, something extraordinary happens:

Digging Wells
The third aliyah of Parshat Toldot presents a profound metaphor through Isaac’s well-digging enterprise. Isaac re-opens his father’s wells, stopped up by the Philistines; then

The Hundredfold Paradox
Dwell in this land. (Genesis 26:3). In famine, with every natural instinct pointing south toward Egypt, Isaac (Yitzḥak) is told to stay. The Midrash notes

The Struggle Within: Neural Landscapes of Jacob and Esau
In the first aliyah of the Torah portion Toldot, the Torah turns inward: before Jacob and Esau become nations, they are in conflict within one

137 — The Coupling of Light and Matter
Chayei Sarah and the Physics of Makifim and Pnimim Synopsis This essay reveals a profound numerical convergence between Torah and quantum physics through the number

Two Wells, Two Ways of Knowing: Seeing the Present, Proving the Past
Summary This essay examines two consecutive narratives from Parshat Vayeira, each featuring a well and each posing a distinct epistemological challenge. Hagar’s well (Genesis 21:19)

The Well That Was Always There
(Parshat Vayeira, Genesis 21:14-21) Hagar and Ishmael are dying of thirst in the desert. In her despair, Hagar places her son under a bush and

The Lessons Taught by the Daughters of Lot
There is not a Shabbos in which we do not read the parasha of Lot (Bereshis Rabbah 51:9) The Kabbalistic Dimension: Hidden Unities and Dimensional

And Sarah Laughed: A Brief Tour of Real Longevity Science
And Sarah laughed within herself, saying, “After I have become worn out, will I have ednah [renewal]?” (Genesis 18:12) Sarah’s laugh is more than skepticism—it

The Fertility of Letters
When G‑d promises great wealth to Abram, after Abram refuses the spoils of war offered by the King of Sodom, Abram retorts: What can You

The Thread That Transforms
Neither from a thread to a sandal-strap, nor will I take from whatever is yours… (Genesis 14:23) After defeating five kings, Abraham (then called Abram)

Loyalty Despite Separation
When Abram heard that his kinsman had been taken captive, he mustered his trained men… and went in pursuit. (Genesis 14:14) Abraham just separated from

After Lot: Why the Blessing Waited
And the Lord said to Avram, after Lot had separated from him… “I will make your seed like the dust of the earth.” (Genesis 13:14–16)

Lekh Lekha, Part II: Go Outside Your Horoscope
Yesterday we spoke about traveling into the self; today, Abraham is told to step outside: And He took him outside, and He said, “Please look

Lekh Lekha: The Journey to the Self
And the Lord said to Abram: Lech lecha—go forth from your land, your birthplace, and your father’s house, to the land that I will show

Dominion After Service
Two diets framed early humanity. In Eden, humans ate only plants; meat was forbidden. The Talmud teaches: Rav Yehuda says that Rav says: Meat was

Noah’s Ark and the Architecture of Creation
The Waters Above and Below Introduction At first glance, the Flood narrative reads like a stark morality tale: humanity sins; G‑d decrees destruction; one righteous

The Tower of Babel
Quanta of Thought | Parashat Noach The story of the Tower of Babel seems, at first glance, like a triumph of human unity. All spoke

Rosh Chodesh Marḥeshvan — Time for Consolidation
Cheshvan[1] is a quiet month with no festivals. Chazal call it Marḥeshvan[2] (“Bitter Ḥeshvan,” because mar means “bitter.”[3]). After the high of Tishrei, with High

The Rainbow That Isn’t There
Everyone marvels at the beauty of a rainbow—its perfect arc, its radiant colors. Yet, in truth, the rainbow doesn’t exist out there. The spectrum of

The Covenant of Light: From One to Many
In the aftermath of the Great Flood, God places a rainbow in the sky as an eternal covenant with humanity. Yet this celestial arc is
The Ark Within
When the world was overwhelmed by chaos, Noaḥ found grace in the eyes of G-d (Genesis 6:8). The Zohar explains that “grace” (ḥein) is a

The Second Adam: From Dust to Silicon
Summary This essay proposes an allegorical (remez) interpretation of Genesis 2, reading the second creation narrative as a prophetic template for humanity’s creation of artificial,
For Myself and For That Guy
This Simchat Torah was the most joyous I have felt in years. News of the hostages’ release on the eve of the holiday lifted mountains
The Day of Superposition
Today is Hoshana Rabbah, the last day of Chol HaMoed Sukkot. Six years ago, I wrote “Chol HaMoed—Days in Superposition,” exploring how these intermediate days

Sweetening Judgments by Entangling Divine Names
VeZot HaBerachah and the Hoshana Rabbah custom of striking the ground with willow twigs tl;dr Incense (ketoret) means “binding,” which we interpret as entanglement; the
From Superposition to Simchah: Sukkot and the Joy of Collapsed Doubt
“Ein simchah ke’hatarat ha-sfeikot”—there is no joy like the resolution of doubt. On the eve of Rosh HaShanah, our sages describe a cosmic pause: the

The Prophecy of Ha’azinu
TL;DR: Ha’azinu’s warning about a “no-people” (b’lo-am) finds chilling relevance in the modern “Palestinian” identity—a political construct created in 1964 by the KGB and Arab
Ha’azinu—Between Heaven and Earth
This week’s parashah is Ha’azinu—Moses’s final song, a duet between heaven and earth that asks creation itself to listen. “Give ear, O heavens… let the
Gott’s Nomen
In many Ashkenazi communities, the day after Yom Kippur is nicknamed Gott’s Nomen, Yiddish for “G-d’s Name.” Chassidic sources associate the four days between Yom
The Ten Days of Nesira: A Mystical Journey of Separation and Union
By Alexander Poltorak לע”נ אבי מורי, אברהם שמשון ע”ה בן ראובן Between the jubilation of Rosh HaShanah and the solemnity of Yom Kippur lie ten
Ten Days of Penitence
The ten days between Rosh HaShanah and Yom Kippur are called Aseret Yemei Teshuvah (Ten Days of Penitence). As the prophet says: Seek G-d while
Shanah Tovah!
Dear Readers and Friends, As we enter the new year, I extend to you heartfelt wishes for a שנה טובה וגמר חתימה טובה—may you and
Shofar and String Theory: Unfolding the Folded Dimensions
I. Introduction Every year on Rosh HaShanah, the raw, unarticulated cry of the shofar cuts through silence. For Kabbalah, that cry is not mere ritual
Welcome to Quantum Torah New Website
My Dear Readers and Friends, It’s hard to believe, but Quantum Torah is turning twenty. When I posted my very first essay back in 2005

Five-Hundred-Year-Journey
Alexander Poltorak Abstract This essay addresses the anigmatic statement of the Jewish Sages, stating that G-d created this world with the letter Heh and the
Ten Systems—Ten Sefirot
… mi‑b’sari echezeh Elokah—From my flesh I behold G‑d (Job 19:26) Introduction – “In His Image” The Torah’s initial description of humanity is both profound and enigmatic:
Korach’s Revolt: a Tale of Symmetry
Korach Revolt Korach, the proto‑egalitarian, cried: All the community are holy… so why do you exalt yourselves? (Numbers 16:3). Chassidut explains that holiness is indeed
The Prophecy of Eldad and Meidad: Connections Between Parshat Behaʿalotekha and the War in Iran
Introduction The Alter Rebbe once remarked in Yiddish, “Leben mit der tzait” (live with the times), meaning that one should live with the current Torah
Urim and Thummim as a Metaphor for Science
By Alexander Poltorak Introduction In the first installment of this essay, “Collapsing the Wave Function of Urim and Thummim,”[1] we discussed the inherent duality of
Tzaraath, Black Holes, and Holographic Principle
By Alexander Poltorak Abstract This essay explores the profound connections between the biblical laws of tzaraath (Leviticus 13-14) and modern concepts of entropy and the
Shemini,Phase Space,Hamiltonian Mechanics: Kabbalah and Physics of Seven and Eight
By Alexander Poltorak Abstract The Torah portion of Shemini records the climactic eighth day of the Tabernacle’s dedication, the moment when divine fire finally descends.
Divine Fine-Tuning and the Evolution of Physical Laws
By Alexander Poltorak Introduction The relationship between the laws of physics and the conditions necessary for life is among the most profound mysteries in both
Measurement Problem or Measurement Blessing?
By Alexander Poltorak I. Introduction Modern physics has revealed a fascinating and perplexing reality at the quantum level, in which particles do not seem to occupy
Did G‑d Create Mathematics?
By Alexander Poltorak “G‑d is a mathematician”Carl Friedrich Gauss I. Can We Prove that G-d created Axioms of mathematics? 1. Introduction A reader challenged me with a

Collapsing the Wave Function of Urim and Thummim
By Alexander Poltorak Dedicated to the refuah shaleimah (a complete and speedy recovery) of David ben Leah And thou shalt put in the breastplate of

Eternity Between the Cherubs
By Alexander Poltorak And there I will meet with you, and I will speak with you from above the cover, from between the two cherubim
Upsherenish: A Defining Moment in a Boy’s Life
By Alexander Poltorak This essay is dedicated to the Upsherenish of our dear grandson, Tzemach Asher Noam, Sheyiḥiyeh, which took place today in Houston. May
The Paradise: A Metaphor for Quantum Mechanics I
By Alexander Poltorak The Tree of Life and the Tree of Knowledge as Metaphors for the Wave Function and Measurement Summary This essay proposes a
Human, Angel, or Machine: The Challenge of Consciousness
By Alexander Poltorak I. Introduction The confrontation between Jacob and an unidentified being in Genesis raises fundamental questions about the nature of consciousness, identity, and
Wrestling with AI: From Divine Dreams to Digital Reality
By Alexander Poltorak This essay is a sequel to the earlier installments, “The Binary Universe II: Angels as Microprocessors,” “Binary Universe III: Two Camps of
The Ontological Ambiguity of Messengers: From Angels to AI
This post continues the discussion we began in “Bereshit: The Binary Universe I” and continued in “The Binary Universe II: Angels as Microprocessors” and “Binary
Binary Universe III: Two Camps of Angels
This post continues the discussion we began in “Bereshit: The Binary Universe I” and continued in “The Binary Universe II: Angels as Microprocessors.” At the
The Binary Universe II: Angels as Microprocessors
Introduction This essay is a sequel to “Bereshit: The Binary Universe I.” The first instalment explored the ideal of a binary universe hinted at by
Four Elements: Four Developmental Stages in the Big Bang Cosmology
Introduction Building upon our interpretation of the four classical elements as developmental stages in the formation of physical reality, we find a remarkable parallel in

Four Classical Elements: Development and Reinterpretation
The parallels we have uncovered between the four elements, the letters of the Tetragrammaton, and the worlds of Seder Hishtalshelut suggest that the ancient sages possessed profound insights into the nature of reality that continue to resonate with modern scientific discoveries. This convergence of ancient wisdom and contemporary understanding offers a path toward a more integrated worldview, where scientific and spiritual perspectives complement rather than contradict each other.
The Imperative of Purpose: Bridging Science, Philosophy, and Divine Wisdom
And G-d said to Abram, “Go forth from your native land and from your father’s house to the land that I will show you.” (Genesis
Sarah in a State of Superposition
And it came to pass, when he was come near to enter into Egypt, that he said unto Sarai his wife: “Behold now, I know
Bereshit: The Binary Universe I
Abstract This essay explores the profound significance of the letter Bet (ב), the first letter of the Torah, and its numerical value of two as
From Kishinev to Amsterdam: Law Enforcement’s Role in Enabling Anti-Jewish Violence
The Guardian, “Israeli football fans attacked after match in Amsterdam” (c) Yesterday, on November 7, 2024, just two days before the anniversary of Kristallnacht, a

And there was Evening and there was Morning: Quantum Mechanics in Genesis
This essay explores a novel parallel between quantum mechanical principles and the biblical creation narrative through etymological analysis of the Hebrew terms “erev” (evening) and “boker” (morning). The study reveals that these terms, which punctuate each day of creation in Genesis, carry meanings that remarkably align with fundamental quantum concepts. “Erev,” rooted in the concept of “mixture,” parallels quantum superposition, while “boker,” stemming from differentiation and discernment, mirrors quantum measurement and wave function collapse.
Sukkah: the Portal into the Holy Land
Sukkah: the portal into the Holy Land Sitting with my wife in our sukkah-hut recently, I was struck by a memory from some four decades ago.
Rosh HaShanah: The Beginning of Change II
Abstract This essay explores the profound connections between language, philosophy, physics, and spirituality in the context of Rosh HaShanah. By examining the linguistic roots of
Rosh HaShanah—the Beginning of Change I
It’s All in the Name Rosh HaShanah is usually translated as the New Year. When translated literally, it means the “Head of the Year.” In
Why Are the Torah’s Mysteries Revealed in Fundamental Theories of Physics?
Look forth from Thy holy habitation, from heaven, and bless Thy people Israel, and the land which Thou hast given us, as Thou didst swear

Bet HaMikdash as a Singularity in Space-time
Introduction In this essay, I intend to draw a parallel between the singularity in space-time, such as the putative point of origin of the universe
Zealotry and Mercy: Parallels Between Pinchas and the War in Gaza
Zealotry and Mercy: Parallels Between Pinchas and the War in Gaza The biblical story of Phinehas (Heb. Pinḥas or Pinchas) presents a complex moral scenario

The Symbolism of the Menorah
The Temple Menorah served as a lighthouse, illuminating darkness and providing purpose and direction.

The Mystery of the Eighth Day
And on the eighth day, the flesh of his foreskin shall be circumcised. Leviticus 12:3 In the Torah portion of Tazria, we are commanded to

Breaking Symmetry to Inaugurate the Priests
The Torah portion Tzav describes a ritual performed by Moses in consecrating Aaron as the High Priest (Kohen Gadol) and his sons as priests (kohanim):

Gazing at the Shekhinah
In his commentary on this week’s Torah Portion, Yitro, Rabbi Chayim Vital, writing in the name of his teacher, the Ari-zal, states that Abel was
Time and Space as Emergent Phenomena — Abstract
The current Torah portion Beshalach tells about the splitting of the Sea of Reeds. As I discussed in my essay, “Collapse and Revelation,” the splitting

On Freedom of Choice, Divine Providence, and the Hard Problem of Philosophy
The story of Joseph and his brothers, described in the Torah portion of Vayeshev, presents many problems. Classical biblical commentators interpret the conflict between Joseph

The Exclusion Principle
Like most Jewish families worldwide, last Shabbat, the conversation revolved around the situation in the Middle East and the war in Gaza. The question was,

Israel’s Security Lapses as a Reflection of Lot Consciousness
The October 7th attack by Hamas terrorists on Israel was a double surprise. The brutality and barbarism of the attack, the unspeakable cruelty of the

Sukkot and the Standard Model
And ye shall take you on the first day the fruit of goodly trees, branches of palm-trees, and boughs of thick trees, and willows of

Principle of Least Action — IV Lagrangian Mechanics
I agree, all its elegance notwithstanding, the principle of least action does not prove the existence of an intelligent Creator. In a sense, when it comes to inanimate matter, the hand of G‑d is concealed, preserving our freedom of choice—to believe or not to believe. However, when it comes to live matter, which, unlike passive inanimate matter, is actively pursuing the goals of survival and procreation, (locally) violating the second law of thermodynamics, there is no more choice. Acknowledging an intelligent Creator, who imbues live matter with goals it must labor to pursue, is no longer a matter of metaphysical commitments, it is a matter of intellectual honesty.

Principle of Least Action III — History
The spectacle of the universe becomes so much the grander, so much more beautiful, the worthier of its Author, when one knows that a small

Principle of Least Action II — Introduction
The spectacle of the universe becomes so much the grander, so much more beautiful, the worthier of its Author, when one knows that a small

Principle of Least Action I
The least action principle is an expression of teleological reasoning where the initial states of the system are determined by the endpoints—the beginning and the end.
Time as a Combination of the Past and the Future
Philosophers struggled with the notion of time from the dawn of human civilization. Physicists of today declared the problem of time the number one problem
Metaphysics of Time in the Eyes of Philosophy and Kabbalah
A-Series and B-Series as Zman and Seder HaZmanim McTaggart’s series A and series B are two conceptual frameworks proposed by the philosopher J.M.E. McTaggart[1] to

Tetragrammaton and the Standard Model
In the first installment of the Standard Model,[1] we uncovered a curious parallel between the arrangement of the elementary particles in the Standard Model (a.k.a.

The Fast of the Seventeenth of Tammuz as a Manifestation of Breaking of the Vessels of Tohu
Today, on the Seventeenth of Tammuz, Jewish people fast to commemorate several tragic events in Jewish history.[1] These tragic events include the breaking of the
Quantum Torah WhatsApp Discussion Group
Open this link to join my WhatsApp Group: https://chat.whatsapp.com/HzeLLjGb05THGWBuQzgj87. This Group is dedicated to the discussion of posts on this blog, issues related to the

Entrainment by the Red Heifer
And for the unclean they shall take of the ashes of the burning of the purification from sin, and running water shall be put thereto
The Standard Model II
In the first installment on the Standard Model, we uncovered a curious parallel between the arrangement of the elementary particles in the Standard Model (a.k.a.

The Standard Model
Introduction What could the Standard Model of particle physics possibly have in common with biblical accounts of the Israelites’ travels in the Sinai Desert, Kabbalistic

Light Above and Light Below
Einstein’s Special Theory of Relativity (STR) is broadly misunderstood by the public. In most popular science books, relativity theory is hailed for introducing relativity to

Translating the Torah for Future Generations
The limits of my language mean the limits of my world. Ludwig Wittgenstein On Rosh Chodesh (the New Moon of the Hebrew month of) Sh’vat,

Cartesian Dualism, Kabbalah, and Quantum Mechanics
Cartesian dualism, or mind-body dualism, formulated by the French scientist, mathematician, and philosopher René Descartes (1596–1650), holds that the body and the mind (which he
Creation—Destruction—Reconstruction
Structurally identical biblical accounts of creation, destruction, and restoration are viewed as a manifestation of dialectic triad thesis-antithesis-synthesis.

The Flood—a Quantum Metaphor
Noah’s flood was a cataclysmic event with no parallels in recorded history. All of humanity (along with flora and fauna)—except for Noah and his family

The Tree of Knowledge as a Quantum-Mechanical Metaphor
To Mendel Almost three years ago, in December of 2019, I posted an essay, “The Tree of Knowledge as a Metaphor for Superposition of States

The History of Creation in Three Words
The history of Creation can be expressed in three words (not even words but mere conjunctions): “and,” “or,” and “and/or,” whereas the history of physics may be expressed in two of them: “or,” and “and/or.”

Curses, Blessings, and Semiconductors
Ki Tavo And it shall come to pass, when the Lord thy God shall bring thee into the land whither thou goest to possess it,
The Captive Beauty
In the proposed allegorical interpretation, the soldier in the war is a metaphor for the Jewish people, who are all “soldiers” in G‑d’s army Tzivot Hashem, who fight the battle against evil to liberate and elevate fallen sparks from Tohu; where the beautiful woman from another nation is a metaphor for a fallen spark from another universe (Tohu), where the uncontrollable attraction the soldier feels towards the beautiful captive is a metaphor for the uncontrollable attraction a Jewish person (who is attuned to spirituality) feels towards divine sparks he is destined to redeem; where after having extracted the fallen spark from the clutches of evil, it requires a period of purification to achieve the ultimate marriage—the reintegration of the fallen spark into the domain of holiness.

The Many Secrets of Mezuzah
This week we study the Torah portion of Eikev, which we will be reading this Shabbat in synagogues. This Torah portion contains the second section

The Temple as a Model of a Cell
Introduction Today, on Tisha B’Av—the ninth day of Av, this year commemorated on the tenth day of Av because the ninth is Shabbat, when mourning

Sefirat HaOmer—A Study in Klal u’Prat
The forty-nine days between Passover and Shavuot are called the days of Sefira or the days of counting Omer—Sefirat HaOmer—when Jews count every day as

On Hidden and Revealed Aspects of Reality
The renowned Kabbalist Rabbi Levi Yitzchak Schneerson, in a 1932 letter to his son, the future Lubavitcher Rebbe, Rabbi Menachem Mendel Schneerson, explained the inner

The Soul – Part IV. The Whole vs. the Parts
This is the fourth installment in the series of essays on the nature of the soul. The first three installments can be found here: What

What is a Soul? III. The Many Souls of Man
…[H]e who tries to cure the soul, wishing to improve the moral qualities, must have a knowledge of the soul in its totality and

What Is a Soul? II. Anatomy of the Soul
In the biblical story of the creation of Adam, the Torah states: Then the Eternal G‑d formed man of the dust of the ground, and
What Is a Soul? I. The Spiritual vs. the Material
Introduction Most Americans believe in an immortal soul.[1] Most scientists think the soul does not exist. Why do so many people believe in an immortal

Three Donkeys
And Abraham rose early in the morning, and saddled his ass. Geneses 22:3 And Moses took his wife and his sons, and set them upon
Zettaflood
In the six hundredth year of Noah’s life, in the second month, on the seventeenth day of the month, on the same day were all

Fill the Earth
And G‑d created man in His own image, in the image of G‑d created He him; male and female created He them. And G‑d blessed

The Cosmological Problem of Initial Conditions and the Universe of Tohu
Now the earth was unformed and void. Genesis 1:2 We have a big problem in cosmology: the problem of the initial conditions of the universe at
Let’s Make this Sukkot About Ananei HaKavod, not about Ananei ha-COVID
During the Holiday of Sukkot, we celebrate the divine providence that protected Jewish people from the sun and other dangers of the desert during their

Yom Kippur—The Day of Pure Delight
Yom Kippur means “The Day of Atonement.” Some view it as a frightening day full of regrets of the past and anxiety for the future.

The Offering of the First Fruits and Loop Quantum Gravity
. . . Thou shalt take of the first of all the fruit of the ground, which thou shalt bring in from thy land that

The Paradox of Steven Weinberg
The world has lost one of the greatest theoretical physicists of our time—Steven Weinberg (1933–2021). I never met him in person. But I studied his
The Genetic Alphabet Has Nothing to Do with the Name of G‑d… Other Than That Everything Has to Do with the Name of G‑d
On this blog, we search for structural parallels between the Torah and science; we look for scientific metaphors that help us to understand the Torah

A Wheel Within a Wheel
Now as I beheld the Chayot [living creatures], behold one Ophan [wheel] at the bottom hard by the living creatures, at the four faces thereof. The

Lag BaOmer Tragedy
A day of joyful festivities turned into a day of tears and mourning. When tragedy strikes, it is not the time for analysis or finger-pointing.

Sanctuaries in Space and Time
We are quite familiar with space—we move freely in space back and forth; we concur space on land and beyond; we reclaim land from sea; we turn deserts into gardens; we turn desolated space into sprawling cities. We are, on the other hand, helpless in the face of time. We cannot move freely in time. We can’t move back in time. We are swept forward in the inexorable flow of time. We do not understand time; we cannot change it. We are masters of land, but not of time. It is for this reason, when G‑d instructed Moses how to build a sanctuary for Himself, He could not have started with time—we would have not the faintest idea what it meant—a sanctuary of G‑d in time—let alone how to do it. That is why G‑d started with space, instructing Moses how to build the Mishkan—a Sanctuary in space—first. Only then He commanded Moses about Shabbat.

Collapse and Revelation
The collapse of the wave function is the process of revealing hidden possibilities. Reducing uncertainty reveals information. Until the wave function collapse, the system is in an uncertain state—the state of superposition. The measurement that causes the collapse of the wave function eliminates this uncertainty revealing the state of the system. The collapse occurs as the result of an experiment or observation. It is the discovery of the state of the system. The process of discovery—revelation—in the terminology of Kabbalah—is the process of revealing Alma d’Isgalya (Revealed World) from Alma d’Iskasya (Hidden World). This is why the splitting of the sea can be seen as an allegory of the collapse of the wave function.

Egyptian Exile as a Metaphor for Compactification in String Theory
And they made their lives bitter with hard service, in mortar and in brick… Exodus 1:14 On a literal level, the Egyptian exile (Galut Mitzrayim)

Jacob in a State of Superposition
And when Jacob made an end of charging his sons, he gathered up his feet into the bed, and expired, and was gathered unto his

Joseph’s Birth—A View From Quantum Mechanics and Biology
And afterwards she bore a daughter, and called her name Dinah. (Genesis 30:21) In my previous essay, “The Conflict Between Joseph And His Brothers—A Gender

The Conflict Between Joseph And His Brothers—A Gender Theory
The confrontation between Joseph and his brothers is one of the most troubling stories of the Bible. Joseph and his brother—twelve sons of Jacob—were the

Jacob’s Struggle With a Man: A Metaphor From Neuroscience
So the present passed over before him; and he himself lodged that night in the camp. And he rose up that night, and took his

On Rachel, Leah, and Dark Energy
Now Laban had two daughters: the name of the elder was Leah, and the name of the younger was Rachel. (Genesis 29:16) Rabbi Isaiah Horowitz (the

Jacob and Esau—Thermodynamics of Order and Chaos
And these are the chronicles of Isaac… (Genesis 25:19) So Esau went unto Ishmael, and took unto the wives that he had Mahalath the daughter

Steering Isaac’s Blessing
And Rebekah spoke unto Jacob, her son, saying: “Behold, I heard thy father speak unto Esau thy brother, saying: Bring me venison, and make me

Keturah and Hagar III—A Metaphor for Unification
And Abraham took another wife, and her name was Keturah. (Genesis 25:1) Keturah: This is Hagar. She was called Keturah because her deeds were as

Hagar and Keturah II—Exegetical Parsimony and Structuralism
And Abraham took another wife, and her name was Keturah. (Genesis 25:1) The Written Torah (Torah shebi-Khtav) tells us only that Abraham took another

Keturah—an Allegory of Entanglement
And Abraham took another wife, and her name was Keturah (Genesis 25:1) As I discussed in the earlier essay, “Yom Kippur – Disentangling the

The Circumcision—The Interference of Parallel Universes
This is My covenant, which ye shall keep, between Me and you and thy seed after thee: every male among you shall be circumcised. And

Akeida in Parallel Universes
Michael Frayn’s 1998 play, Copenhagen, concerns a meeting between two great physicists, Niels Bohr and Werner Heisenberg, in 1941 in Copenhagen. In this play, the

The Akeida — The Binding of Isaac
And He said: “Take now thy son, thine only son, whom thou lovest, even Isaac, and get thee into the land of Moriah; and offer

Abraham and Lot—A Story of Decoherence
So Abram went, as the Eternal had spoken unto him; and Lot went with him… And Abram took Sarai his wife, and Lot his brother’s

Noah’s Ark—Three Layers of Reality
A light shalt thou make to the ark…with lower, second, and third stories shalt thou make it. (Genesis 6:16) We mentioned in the previous posts

Noah’s Ark—Three Layers of Being Human
A light shalt thou make to the ark, and to a cubit shalt thou finish it upward; and the door of the ark shalt thou

Noah’s Ark—A Model of a Living Cell
Make thee an ark of gopher wood; with rooms shalt thou make the ark, and shalt pitch it within and without with pitch” (Genesis 6:14)

Let There Be Light
And G‑d said: “Let there be light.” And there was light. And G‑d saw the light, that it was good; and G‑d separated between the

Tzimtzum III—Renormalization—Sweeping Infinites Under the Rug
Sweeping Infinities Under the Rug—or Renormalization Having dealt with internal contradictions in the previous section (see Physics of Tzimtzum I — The Quantum Leap and

Nobel Prize for Research on Black Holes
Congratulations to Roger Penrose, Reinhard Genzel, and Andrea Ghez for wining the 2020 Nobel Prize in Physics for their contributions to establishing the existence of

Physics of Tzimtzum II — Collapse of the Wave Function
In the previous post “Physics of Tzimtzum I—The Quantum Leap”, we gave a general overview of the mystical doctrine of tzimtzum—the cornerstone of Lurianic Kabbalah.

Physics of Tzimtzum I — The Quantum Leap
Introduction “In the beginning G‑d created the heavens and the earth.” (Genesis 1:1) “In the beginning G‑d created the heavens and the earth,” the Torah

Quantum Cheshire Cat vs. Venomous Snakes
A Study in Form and Matter And Moses prayed for the people. And the Eternal said unto Moses: “Make thee a fiery serpent, and set it

Getting a Blessing Through a Wormhole
And it came to pass on the morrow, that Moses went into the tent of the testimony; and, behold, the rod of Aaron for the

My Name Is G‑d, and I Am Pleased to Make Your Acquaintance
In the beginning, G‑d created the heaven and the earth…[1] (Genesis 1:1) Classical biblical commentators have given the first words of the Torah many

Shavuot (in Russian)
Шавуот Праздник Дарования Торы Aлександр Полторак Закончился праздник Песах. Все евреи поспешно убрали пасхальную посуду в особые шкафы или на чердаки до следующего Песаха.

The Soul is in the Blood
For the life of the flesh is in the blood.” (Leviticus 17:11) The word translated here as “life” in the Hebrew original is nefesh, i.e.,

Counting Weeks and Days
There is a Biblical Commandment to count the days between the Passover and Shavuot, the “Feast of Weeks” (a.k.a. Pentecost). We start counting on the

Nadab and Abihu — Tragedy in Time
And Nadab and Abihu, the sons of Aaron, took each of them his censer, and put fire therein, and laid incense thereon, and offered strange

Salt: The Covenant of the Opposites
And every meal-offering of thine shalt thou season with salt; neither shalt thou suffer the salt of the covenant of thy G‑d to be lacking

The Surrounding Light and the Penetrating Light
The Torah portion Vayakhel deals with the construction of the Mishkan, i.e., the “Tabernacle.” In Kabbalah, the Mishkan is viewed as a microcosm that represents
Wigner’s Friend Receives a Death Threat
It is related that on the day that Rabbi Yehuda HaNasi died, the Sages decreed a fast, and begged for divine mercy so that he

Ki Tisa Hints at the Coronavirus
On the Eve of Shabbat, we received a government mailing containing documents that we were required to fill out and send back to the Census

In the Beginning — It’s All About Change
In the beginning G‑d created the heaven and the earth. (Genesis 1:1) The first verse in the Torah is key to understanding the fundamentals

Abel and Cain Conflict—Wave-Particle Duality
…And Abel was a keeper of sheep, but Cain was a tiller of the ground. And in process of time it came to pass, that Cain

Primordial Serpent—the Incurable Atomist
Now the Serpent was more cunning than any beast of the field which the Eternal G‑d had made. (Genesis 3:1) When G‑d placed Adam

It Is Not Good For Man To Be Alone
And the Eternal G‑d said: “It is not good that the man should be alone; I will make him a helpmate opposite him.” (Genesis 2:18)

Cosmology and the Tetragrammaton
As we discussed in the previous post “Singularity and Paradise,” Paradise offers a beautiful metaphor for modern cosmology wherein Eden is the initial singularity preceding

Singularity and Paradise
These are the chronicles of the heaven and of the earth when they were created, in the day that the Eternal G‑d made earth and

The Tree of Life and Wave Mechanics
As we discussed in the earlier post, The Tree of Knowledge as a Metaphor for Superposition of States and Heisenberg’s Uncertainty Principle, the Heisenberg uncertainty

Why the first humans were not allowed to eat from the Tree of Knowledge
As always in science, every answered question breeds new questions. Now that we understand that the Tree of Life and the Tree of Knowledge are

The Tree of Knowledge as a Metaphor for Superposition of States and Heisenberg’s Uncertainty Principle
And out of the ground made the Lord G‑d to grow every tree that is pleasant to the sight, and good for food; and the
The Primacy of the Prime Numbers
And the messengers returned to Jacob, saying: “We came to thy brother Esau, and moreover he cometh to meet thee, and four hundred men with

Three Angels: Past, Present, and Future
And the Lord appeared unto him in the plains of Mamre, as he sat in the entrance of the tent in the heat of the
Stress-testing the judgment
And Abraham drew near, and said: ‘Wilt Thou indeed sweep away the righteous with the wicked? Perhaps there are fifty righteous within the city; wilt

Noah’s Ark — Sailing through the Flood of Time
Time is a storm in which we are all lost. ” (William Carlos Williams, Introduction to “Selected Essays”) I always had a hard time relating

Cosmic Symphony
Strings vibrate, Souls tremble, Angels are running and returning, G‑d is touching and not touching – The rhythms of the universe… Nothing stays still… all

Noah — the First Inventor
At the end of the first chapter of the Torah, Genesis (Bereshit), G‑d regrets, as it were, creating humanity that became depraved: And the Lord

Sukkot — Bringing Time into Space
Jews have a very strange custom to take four species (Heb. arba’a minim)—a fruit of a citron tree (etrog), a branch of a date palm (lulav), boughs from the myrtle tree (chadassim),

Chol Hamo’ed — Days in Superposition
Today is Chol Hamo’ed Sukkot – the intermediate days between the first and the last days of the holiday of Sukkot. These days are not

The Land We Married
And the Lord spoke unto Moses, saying: ‘Command the children of Israel, and say unto them: When ye come into the land of Canaan, this

Daughters of Zelophehad
Then drew near the daughters of Zelophehad …. of the families of Manasseh, the son of Joseph; and these are the names of his daughters:

Ẓiẓit, Koraḥ, and Wave-Particle Duality
The Lord spoke to Moses, saying: Speak to the children of Israel and you shall say to them that they shall make for themselves fringes

Fitting Pieces of the Puzzle Together
Meditations on the Maaseh Merkavah – IV This is the fourth and the final installment in the series of posts related to Ezekiel’s prophesy, Ma’aseh
Futurist Interpretation of Quantum Mechanics
(A popular summary of the paper “Towards Futuristic Interpretation of Quantum Mechanics” by Alexander Poltorak being currently prepared for publication) Quantum mechanics (QM) is one
Collapse of the Wave Function
Meditations on the Maaseh Merkavah – III This is the third installment in the series of posts related to the Ezekiel’s prophesy, Maaseh Merkava, “The

Relational Space
Meditations on the Maaseh Merkavah – II This post is a sequel to my previous post, “Space – Between Future and Past.” For background information,

Space – Between the Future and the Past
Meditations on the Maaseh Merkavah – I We do science by studying nature. We study physics in a lab, peering into space or working out

Ten Sephirot and Special Relativity
The Special Theory of Relativity, published by Albert Einstein in 1905, was a game changer. It ushered the era of new physics dubbed by some

The Entangled Tenth
And all the tithe of the herd or the flock, whatsoever passeth under the rod, the tenth shall be holy unto the Lord.” (Leviticus 27:32)

Unified Field Theory and the Dew of Resurrection
And ye shall take you on the first day the fruit of goodly trees, branches of palm-trees, and boughs of thick trees, and willows of
Information Asymmetry as a Cause of Antivaxxer Movement
It’s easy to blame anti-vaxxers. But should we? They come from a good place – they want to protect their children. As parents, we make

Adultery and Monogamy of Entanglement
And whosoever lieth carnally with a woman, that is a bondmaid, designated for a man, and not at all redeemed, nor was freedom given her;
Ye shall be disentangled… but not disengaged
In my post, “Ye Shall be Disentangled,” I suggested that the verse: “Ye shall be holy, for I, the Lord, your G‑d, am holy” (Levit.

Wigner’s Friend Paradox
Amicus est Socrates, magister meus, sed magis est amica veritas. “Socrates is my friend but a greater friend is truth” – Plato c. 428-348 BCE.

The Puzzle of Pi
March 14 is celebrated by nerds around the world as the Pi Day. When written in digits, 3/14 represents first three digits of the number
Quantum Torah Film Premiere
Welcome to the premiere of our first film, Quantum Torah. You can watch the film here: Don’t forget to subscribe to my channel here:
* “Qabala” spelling for Kabbalah used intentionally for the Quanta pun.
